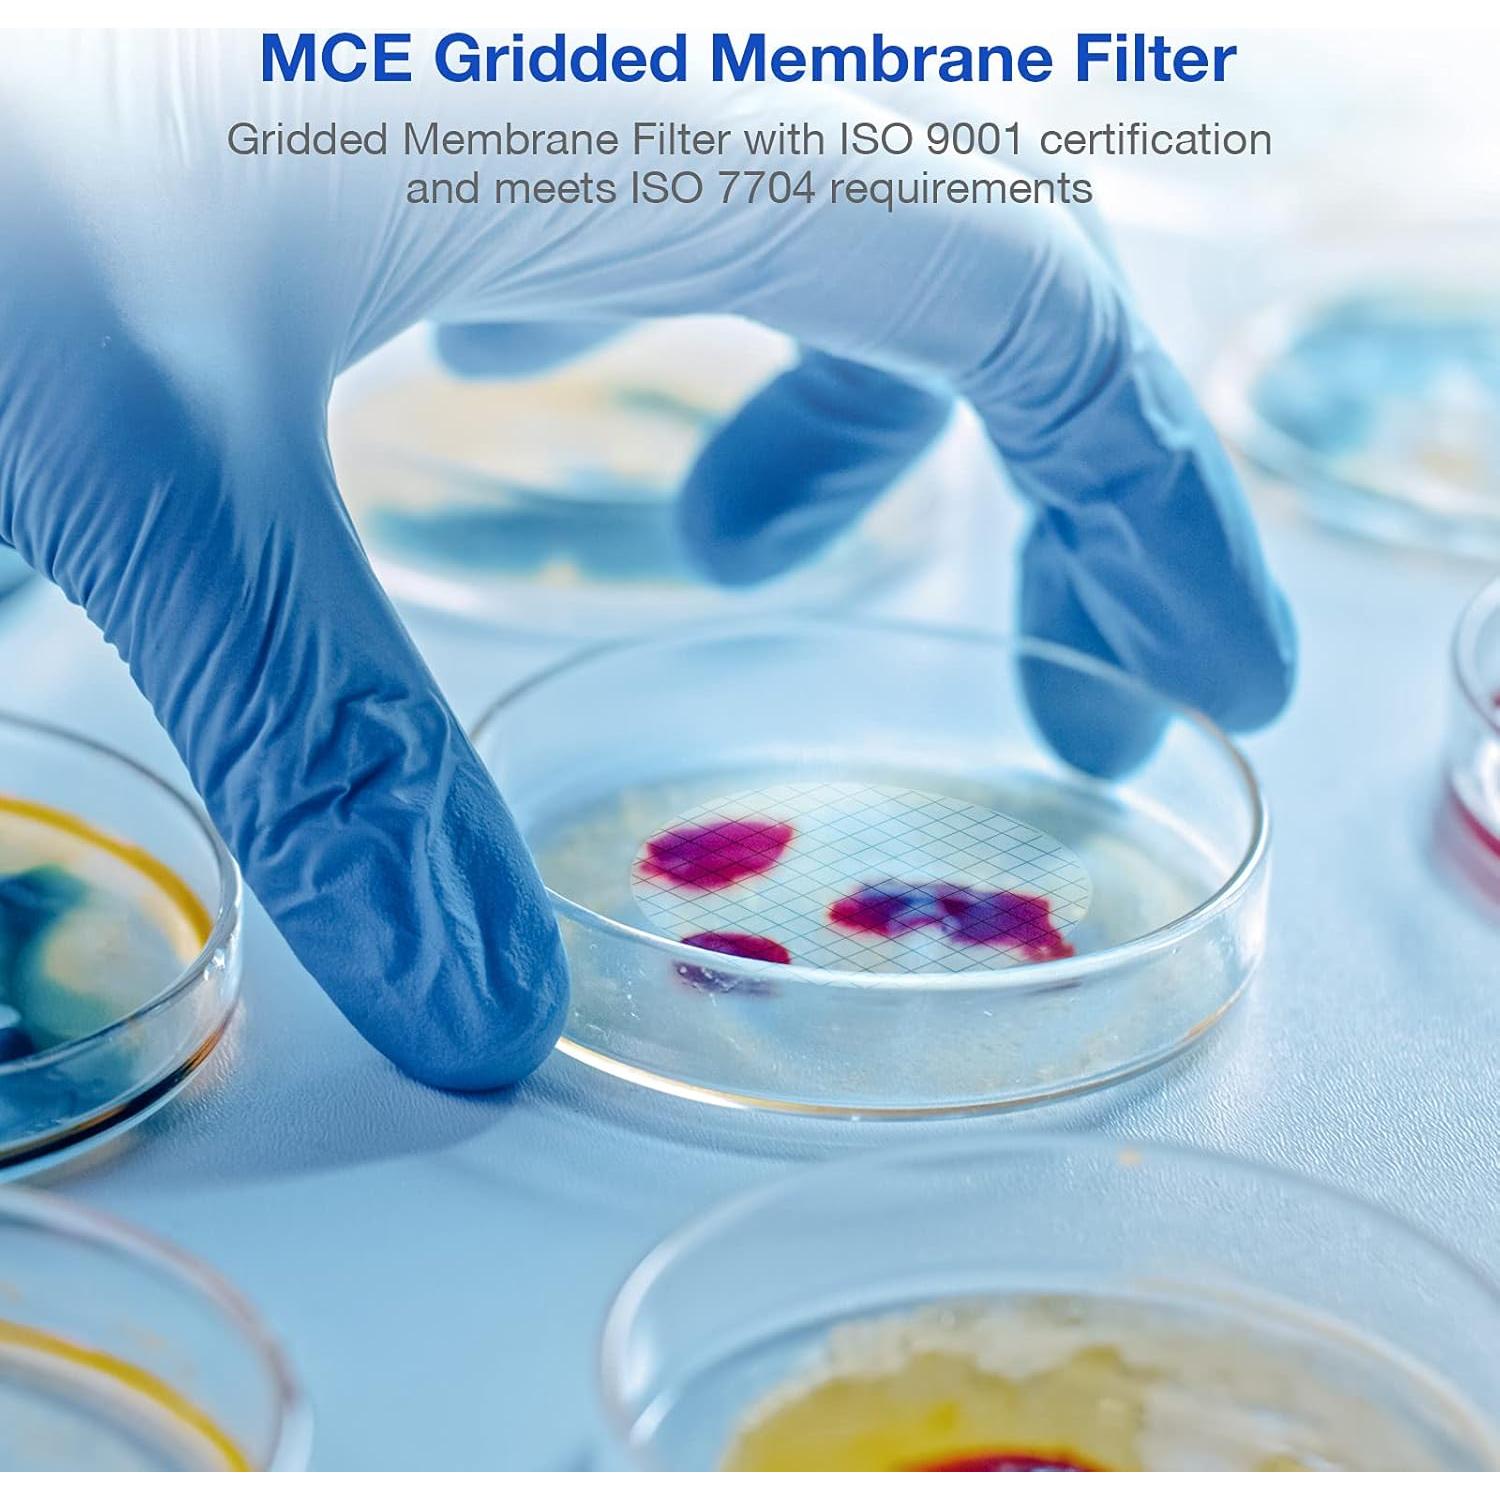
Filtro de Membrana Estéril SimPure MCE 47mm 0.45um Paquete 100
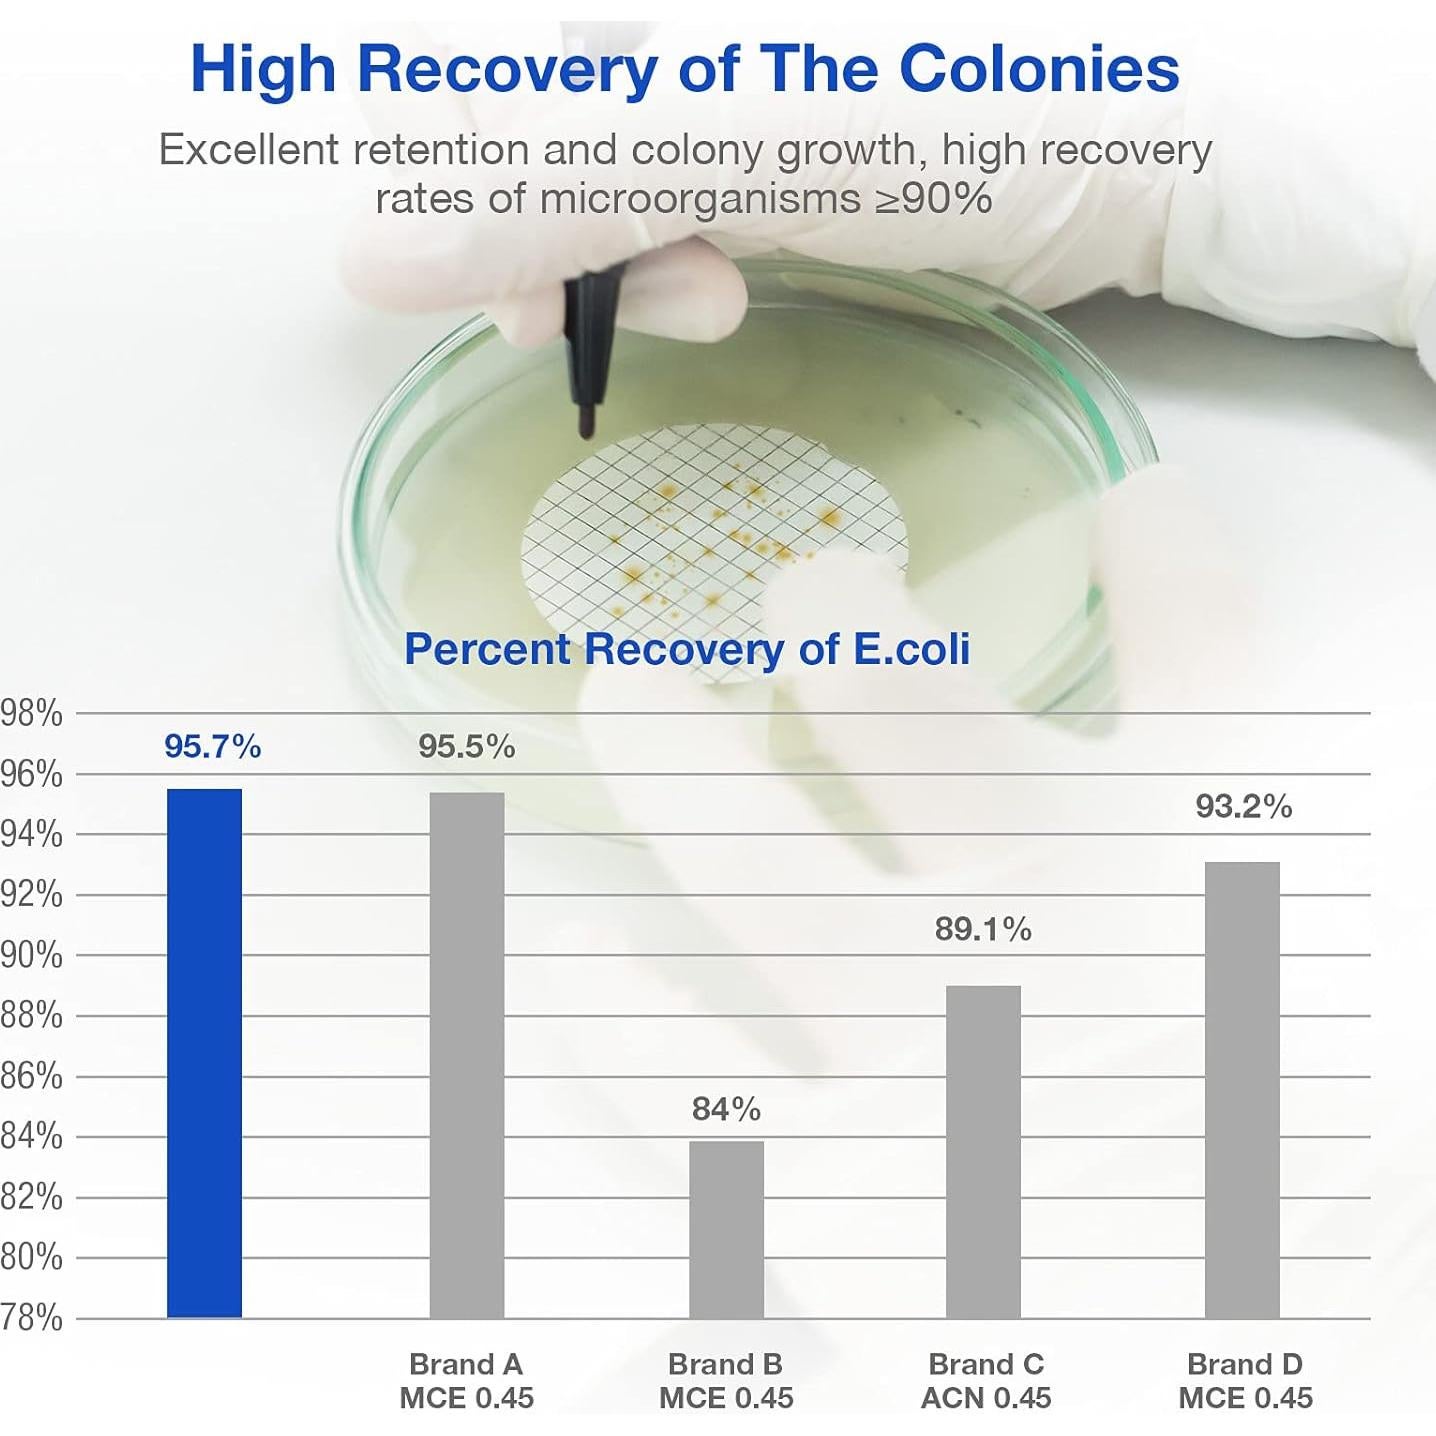
Filtro de Membrana Estéril SimPure MCE 47mm 0.45um Paquete 100

Pirate Face Tattoo
Filtro de Membrana Estéril SimPure MCE 47mm 0.45um Paquete 100

Filtro de Membrana Estéril SimPure MCE 47mm 0.45um Paquete 100
$64.461
5% OFF+ impuestos: $13.537
- Compra protegida
- Envío a todo el país
- Garantía de entrega
Características destacadas
- El filtro de membrana de éster de celulosa mixta (MCE) SimPure está compuesto de acetato de celulosa y nitrato de celulosa. La membrana MCE es biológicamente inerte, es una de las membranas más utilizadas en aplicaciones analíticas y de investigación
- Los filtros con rejilla tienen líneas de rejilla claramente definidas espaciadas a intervalos de 3.1 mm. La tinta especial utilizada es no tóxica y completamente libre de inhibidores de crecimiento bacteriano
- Las membranas de éster de celulosa mixta (MCE) con rejilla son ideales para el conteo de colonias y pruebas de esterilidad
- Las líneas de rejilla en la superficie de la membrana eliminan la fatiga visual durante el conteo de colonias sin afectar el crecimiento de las colonias. Y permiten que las reacciones de color se observen fácilmente
- Las membranas MCE estériles con rejilla son membranas no soportadas, naturalmente hidrofílicas
Opiniones de compradores
61 opiniones
Garrett Brown
Son como se describen y como en la imagen.
Asad
Quería filtrar el colorante fluoresceína no disuelto/suspendido del agua. Fallé completamente en el filtrado porque simplemente no permitía que el agua fluyera a través de él.
Jose Bautista
Este es un gran producto, hasta ahora funciona como las membranas de las mejores marcas. Tené en cuenta que esta es una filtración de membrana económica, lo que significa que la mayoría de las cosas protectoras que tienen otras marcas faltan aquí. Tenés que ser más cuidadoso en el manejo y almacenamiento, pero la diferencia de precio hace que valga la pena el esfuerzo.
Stacey
Buenos filtros, cumplen con su función, vienen bien empaquetados y tienen un buen precio en comparación con la competencia.
AquaChem
Compramos estos para realizar pruebas de filtración de membrana fecal termotolerante. Funcionan de manera comparable a los que usamos anteriormente de Fisher Scientific, que costaban el doble que estos. ¡Son una gran opción!
Especificaciones técnicas
- Fabricante
- Alberts Filter
- Dimensiones del paquete
- 3.5 x 3.25 x 1.75 pulgadas (8.89 x 8.26 x 4.45 cm); 3.99 onzas (113.4 gramos)
- Número de modelo del artículo
- FMCE047045GWS-100P
- Está descontinuado por el fabricante
- No
Preguntas y respuestas
Tu pregunta fue enviada. Te responderemos pronto.
¿Dónde te enviamos la respuesta?
Tus preguntas
· Recibirás la respuesta a
Productos relacionados
Debrox
Debrox Gotas Eliminación Cerumen 15 ml Paquete de 2
Pure Ponta






